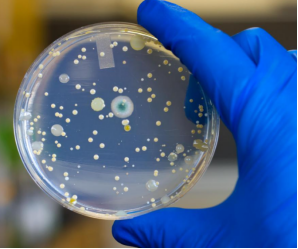
image.png

生物组织冻干技术及样本保存
- 上海田枫实业有限公司2025年9月24日 8:39 点击:63
生物组织冻干技术及样本保存
生物组织冻干技通过将生物组织在低温下冻结,然后在真空环境中将水分直接升华成气态,从而去除水分。保留生物组织的结构和功能,延长样本的保存时间。
冻干机的低温环境可以有效减缓生物分子的降解速度,保护生物组织的活性和结构完整性。真空环境,加速水分升华,防止生物组织在冻干过程中受到氧化和热损伤。
传统的干燥方法往往会破坏生物组织中的营养成分和活性物质,而冻干则能够在去除水分的同时,大限度地保留这些成分。
冻干机操作简便。配备了直观的操作界面,可以轻松设置和监控冻干过程。同时,我们的冻干机还具备多重安全保护功能,确保操作过程的安全性。

作为冻干机设备的厂商,我们致力于为客户提供高性能、高可靠性的冻干机设备。帮助客户有效保存生物组织,保留其营养成分和生物活性物质。
联系邮箱:kefu@labbase.net
版权与免责声明
- 凡本网注明“来源:来宝网”的所有作品,版权均属于来宝网,转载请必须注明来宝网, https://www.labbase.net,违反者本网将追究相关法律责任。
- 本网转载并注明自其它来源的作品,目的在于传递更多信息,并不代表本网赞同其观点或证实其内容的真实性,不承担此类作品侵权行为的直接责任及连带责任。其他媒体、网站或个人从本网转载时,必须保留本网注明的作品来源,并自负版权等法律责任。
- 如涉及作品内容、版权等问题,请在作品发表之日起一周内与本网联系,否则视为放弃相关权利。



